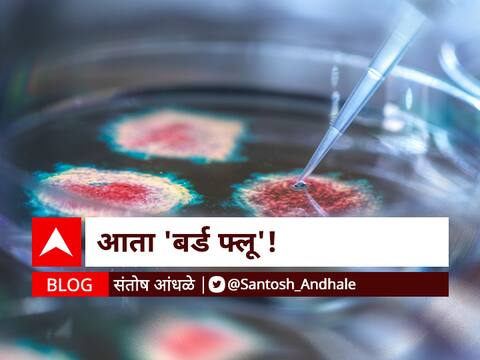
#

एक्स्प्लोर
संतोष आंधळे
ज्येष्ठ पत्रकार, वरिष्ठ संपादक (माय मेडिकल मंत्रा)
All Authors
Advertisement
Advertisement

नरेंद्र बंडबे
Opinion